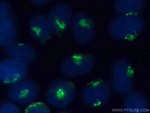
golgin 97 Antibody in Immunocytochemistry (ICC/IF)

Search
Proteintech
golgin 97 Polyclonal Antibody
{{$productOrderCtrl.translations['antibody.pdp.commerceCard.promotion.promotions']}}
{{$productOrderCtrl.translations['antibody.pdp.commerceCard.promotion.viewpromo']}}
{{$productOrderCtrl.translations['antibody.pdp.commerceCard.promotion.promocode']}}: {{promo.promoCode}} {{promo.promoTitle}} {{promo.promoDescription}}. {{$productOrderCtrl.translations['antibody.pdp.commerceCard.promotion.learnmore']}}
产品信息
12640-1-AP
种属反应
已发表种属
宿主/亚型
分类
类型
抗原
偶联物
形式
浓度
规格
纯化类型
保存液
内含物
保存条件
运输条件
产品详细信息
The MW of this protein is 97 kDa, and 12640-1-AP specifically recognizes the 97 kDa protein. IF result shows strong Golgi staining.
Immunogen sequence: QIVALERMR AADQTTAEQG MRQLEQENAA LKECRNEYER SLQNHQFELK KLKEEWSQRE IVSVAMAQAL EEVRKQREEF QQQAANLTAI IDEKEQNLRE KTEVLLQKEQ EILQLERGHN SALLQIHQLQ AELEALRTLK AEEAAVVAEQ EDLLRLRGPL QAEALSVNES HVTSRAMQDP VFQLPTAGRT PNGEVGAMDL TQLQKEKQDL EQQLLEKNKT IKQMQQRMLE LRKTLQKELK IRPDNELFEV REKPGPEMAN MAPSVTNNTD LTDAREINFE YLKHVVLKFM SCRESEAFHL IKAVSVLLNF SQEEENMLKE TLEYKMSWFG SKPAPKGSIR PSISNPRIPW S (418-767 aa encoded by BC032853)
靶标信息
The Golgi apparatus, which participates in glycosylation and transport of proteins and lipids in the secretory pathway, consists of a series of stacked cisternae (flattened membrane sacs). Interactions between the Golgi and microtubules are thought to be important for the reorganization of the Golgi after it fragments during mitosis. The Golgins are a family of proteins, of which the protein encoded by this gene is a member, that are localized to the Golgi. This encoded protein is associated with Sjogren's syndrome.
仅用于科研。不用于诊断过程。未经明确授权不得转售。
生物信息学
蛋白别名: gap junction protein, alpha 4, 37kD; golgi autoantigen, golgin subfamily a, 1; Golgin subfamily A member 1; Golgin-97; unnamed protein product
基因别名: 0710001G09Rik; 2210418B03Rik; AW107649; GOLGA1; Golgi97; golgin-97
UniProt ID: (Human) Q92805, (Mouse) Q9CW79
Entrez Gene ID: (Human) 2800, (Mouse) 76899